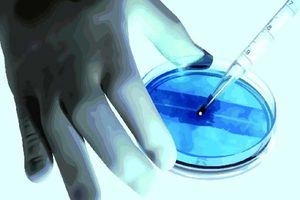

Doc, I have genital warts. Am I at risk of cancer?

Genital warts are a common symptom of HPV infection that can be uncomfortable or painful. They can disappear over time, but treatment is essential in preventing their return and possible complications. PHOTO | FILE
What you need to know:
- A few types of the HPV virus have a strong link with cervical cancer.
- HPV has also been associated with cancers of the vagina, vulva, anus, penis, mouth and throat (oropharyngeal cancer).
Hello Dr Flo,
I have some soft growths on my private parts that I think are warts even though I have not gone for a check-up. They are black in colour and they keep growing bigger, but they are not painful. Is there a way to get rid of them? Will I get cervical cancer? Please advise
Milly
Dear Milly,
Human Papilloma Virus (HPV) is the virus that causes growth of warts. The warts can grow on skin on any part of the body and also on mucus membranes. They are transmitted through skin to skin contact.
Many times the body clears the HPV infection before warts can develop. Once warts develop, most heal by themselves over time. There are medications that can be prescribed by a doctor, to be applied directly on the warts such as podophyllin, imiquimod, trichloroacetic acid and salicylic acid. In case the warts don’t disappear with these treatments, they may be removed by cryotherapy, electrocautery, laser removal or through surgery.
A few types of the HPV virus have a strong link with cervical cancer. HPV has also been associated with cancers of the vagina, vulva, anus, penis, mouth and throat (oropharyngeal cancer). Very few people who have HPV or warts will get cancer and HPV is usually not the only risk factor. There are vaccines that are used to protect against the strains of HPV that are more likely to cause genital warts or cervical cancer.
Hi Doc,
I always itch for about 10 minutes after taking a cold shower. How can I stop this?
Belle
Dear Belle,
You have aquagenic pruritus, which means itching caused by water, a kind of allergy to water. Contact with water produces an intense itching of the skin, usually with a prickling sensation, without any observable rash or swelling. The symptoms can last anywhere from 10 minutes to two hours and it usually resolves on its own.
There is no good reason why some people develop this problem though sometimes it may be associated with underlying blood conditions. Showering with hot water for some people actually prevents the itching because the heat affects the cells (mast cells) that trigger the allergic reaction. But if you take a hot shower that is too hot and for too long, you can also get itching because of drying out of the skin.
You can use anti-allergy tablets and creams/lotions for the itching, like piriton, though they do not work very well. Avoid using harsh soaps for bathing or harsh detergents for your towels because the chemicals in the soap can also cause the itching; and clean your towel regularly, like once or twice a week, to avoid growth of bacteria on a damp towel. The condition cannot be cured, unfortunately.
Dear Doc
I am 47 years old. Since mid-February I have been experiencing burning pain on the bottom of my feet. Especially on my right heel. What might be causing this? Should it worry me? What are the remedies?
Amm
Dear Amm
The burning sensation on the heels is most likely due to irritation/inflammation of the heel bone (calcaneus) or the structures attached to or around it, including tendons, muscles and nerves. It could also be due to reduction or inflammation of the heel pad, which is the fatty pad on the bottom of the foot that acts as a cushion for the foot.
However, in most cases, burning heel pain is due to plantar fasciitis, which means inflammation of the fascia on the bottom of your foot. The plantar fascia is like a sheet of fibrous tissue that connects the heel to the front of the foot, where the toes start. It supports the foot, helping us walk by acting as a shock absorber. It can easily get injured or torn due to too much pressure on the feet. Sometimes the constant damage and repair process from the fasciitis leads to formation of a bony growth on the heel bone called a calcaneal or heel spur, which can be seen when an x-ray of the foot is done. The spur itself is a consequence of the prolonged stress on the bone, and not the main problem.
Fasciitis may cause pain, usually after starting to walk after sitting or lying down for long, or after being on your feet for long. It is more common in those who are overweight or obese, those whose jobs require them to stand or walk for long durations of time and also long distance runners. It can also occur during late pregnancy and in those with flat feet or a high foot arch. Wearing shoes with poor arch support also contributes to the problem.
To manage it, reduce the pressure on your feet by reducing the walking and standing. You can stretch and massage your feet before getting out of bed in the morning and after being on your feet for long. Wear shoes with good arch support and a cushioning sole. You can also add orthotic insoles. Pain killers also help to reduce the pain and inflammation. It is beneficial to see a physiotherapist to help with the exercises for the feet and legs and also advice on various devices and methods that can be used to reduce the pain and prevent worsening. It is advisable to be reviewed by an orthopaedic specialist for prescription of medications and other supportive measures. Other treatments that the orthopedist may recommend include steroid injections, using splints, plantar iontophoresis (using an electric current to get an applied drug to get into the foot), extracorporeal shock wave therapy and surgery, where necessary.
Send your questions to [email protected]